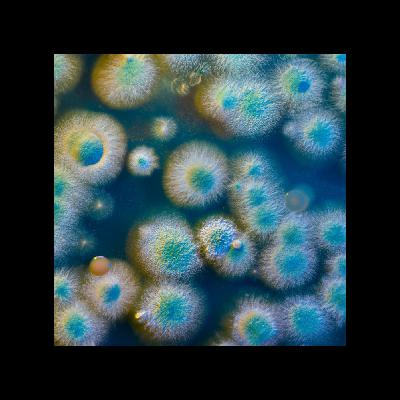

Discover
エダンズ論文ナビ 科学のワクワクを世界へ (EXCITED by the SCIENCE)
42 Episodes
Reverse
このエピソードでは、血液学のエキスパートであるマリア博士が、「低リスク骨髄異形成症候群(MDS)の治療法」に関する最新研究を分かりやすく解説します。また、このエピソードを通じて、臨床研究を設計する際のコツについても理解することができます。 🔍このエピソードは以下の方にオススメです ・科学論文の執筆において、より効果的なコミュニケーションを目指す研究者 ・研究成果を国際的な学術誌で発表する予定の大学院生およびポスドク ・科学コミュニケーションに興味のある方々 ✅ チャンネルについて 科学の進歩は私たちの生活を豊かにし、未来を形作ります。一流の研究者が発信するこのチャンネルでは、最新の研究論文や論文執筆のコツをわかりやすくお伝えします。科学のワクワク感を共有し、一緒に新しい発見の旅に出かけましょう! Facebookはこちら→ https://www.facebook.com/EdanzJP/ 見たい、読みたい方向けに様々な方法で発信中→ https://jp.edanz.com/multimedia ブログはこちら→ https://jp.edanz.com/blog #MDS治療 #ルスパテルセプト #臨床試験設計 #血液学 #骨髄異形成症候群 ✅ 目次 0:00 骨髄異形成症候群(MDS)の概要 2:00 既存治療薬エリスロポエチンの課題 2:35 新たな治療薬ルスパテルセプトの効果を検証する方法 4:08 ルスパテルセプトの効果と副作用
このエピソードでは、環境科学のエキスパートであるティナ博士が、「気候変動と人間の活動による人間とげっ歯類の相互作用の変化」に関する最新研究を分かりやすく解説します。また、このエピソードを通じて、インパクト・ステートメントの重要性についても理解することができます。 🔍このエピソードは以下の方にオススメです ・科学論文の執筆において、より効果的なコミュニケーションを目指す研究者 ・研究成果を国際的な学術誌で発表する予定の大学院生およびポスドク ・科学コミュニケーションに興味のある方々 ✅ チャンネルについて 科学の進歩は私たちの生活を豊かにし、未来を形作ります。一流の研究者が発信するこのチャンネルでは、最新の研究論文や論文執筆のコツをわかりやすくお伝えします。科学のワクワク感を共有し、一緒に新しい発見の旅に出かけましょう! Facebookはこちら→ https://www.facebook.com/EdanzJP/ 見たい、読みたい方向けに様々な方法で発信中→ https://jp.edanz.com/multimedia ブログはこちら→ https://jp.edanz.com/blog #環境科学 #ワンヘルス #インパクトステートメント ✅ 目次0:00 ワンヘルスという概念の解説1:33 モザンビークで行ったインタビューベースの研究内容2:08 インパクト・ステートメントの重要性 3:06 人間とげっ歯類の健康上の相互関係
このエピソードでは、医学・健康科学のエキスパートであるピーター博士が、「テレリハビリテーションを支える活動認識の最新モデル」に関する最新研究を分かりやすく解説します。また、このエピソードを通じて、サステナブルな研究デザインを実現するためのコツについても理解することができます。 🔍このエピソードは以下の方にオススメです ・科学論文の執筆において、より効果的なコミュニケーションを目指す研究者 ・研究成果を国際的な学術誌で発表する予定の大学院生およびポスドク ・科学コミュニケーションに興味のある方々 ✅ チャンネルについて 科学の進歩は私たちの生活を豊かにし、未来を形作ります。一流の研究者が発信するこのチャンネルでは、最新の研究論文や論文執筆のコツをわかりやすくお伝えします。科学のワクワク感を共有し、一緒に新しい発見の旅に出かけましょう! Facebookはこちら→ https://www.facebook.com/EdanzJP/ 見たい、読みたい方向けに様々な方法で発信中→ https://jp.edanz.com/multimedia ブログはこちら→ https://jp.edanz.com/blog #テレリハビリテーション #活動認識技術 #リハビリテーション研究 #サステナブル研究 #医学革新 ✅ 目次 0:00 テレリハビリテーションの概要 1:08 テレリハビリテーションを支える活動認識技術 2:02 ディープラーニングと最新技術を用いた方法論 3:02 最新技術の活動認識能力 3:53 プライバシーに配慮した研究デザイン
このエピソードでは、環境科学のエキスパートであるティナ博士が、「生態系を保護するための政策の評価」に関する最新研究を分かりやすく解説します。また、このエピソードを通じて、政策の評価方法についても理解することができます。 🔍このエピソードは以下の方にオススメです ・科学論文の執筆において、より効果的なコミュニケーションを目指す研究者 ・研究成果を国際的な学術誌で発表する予定の大学院生およびポスドク ・科学コミュニケーションに興味のある方々 ✅ チャンネルについて 科学の進歩は私たちの生活を豊かにし、未来を形作ります。一流の研究者が発信するこのチャンネルでは、最新の研究論文や論文執筆のコツをわかりやすくお伝えします。科学のワクワク感を共有し、一緒に新しい発見の旅に出かけましょう! Facebookはこちら→ https://www.facebook.com/EdanzJP/ 見たい、読みたい方向けに様々な方法で発信中→ https://jp.edanz.com/multimedia ブログはこちら→ https://jp.edanz.com/blog #政策評価研究 #政策評価方法 #生態系保護政策 ✅ 目次 0:00 オープニング 0:10 生物の多様性損失を保護するための研究の紹介 1:28 絶滅の危機に瀕するサメ・エイの特徴 2:15 政策を評価する際の方法論 3:17 漁業管理政策が生態系保護に与える影響とは?
このエピソードでは、生物学のエキスパートであるイサ博士が、「昆虫が街灯のような人工灯に群がる理由」に関する最新研究を分かりやすく解説します。また、このエピソードを通じて、査読コメントを研究の改善に活用するコツについても理解することができます。 🔍このエピソードは以下の方にオススメです ・科学論文の執筆において、より効果的なコミュニケーションを目指す研究者 ・研究成果を国際的な学術誌で発表する予定の大学院生およびポスドク ・科学コミュニケーションに興味のある方々 ✅ チャンネルについて 科学の進歩は私たちの生活を豊かにし、未来を形作ります。一流の研究者が発信するこのチャンネルでは、最新の研究論文や論文執筆のコツをわかりやすくお伝えします。科学のワクワク感を共有し、一緒に新しい発見の旅に出かけましょう! Facebookはこちら→ https://www.facebook.com/EdanzJP/ 見たい、読みたい方向けに様々な方法で発信中→ https://jp.edanz.com/multimedia ブログはこちら→ https://jp.edanz.com/blog #生物学 #科学 #自然 #化学 ✅ 目次 0:00:論文の概要の紹介 1:11:昆虫が人口灯に群がる驚きの理由とは? 2:54:最新研究が現代社会において重要な意味を持つ理由 3:23:査読コメントを活用するためのTips
このエピソードでは、バイオサイエンスのエキスパートであるスコット博士が、「医療資源が不足する遠隔地で使用可能なルミノメーターの開発」に関する最新研究を分かりやすく解説します。また、このエピソードを通じて、研究をオープンソース化することのメリットについても理解することができます。 🔍このエピソードは以下の方にオススメです ・科学論文の執筆において、より効果的なコミュニケーションを目指す研究者 ・研究成果を国際的な学術誌で発表する予定の大学院生およびポスドク ・科学コミュニケーションに興味のある方々 ✅ チャンネルについて 科学の進歩は私たちの生活を豊かにし、未来を形作ります。一流の研究者が発信するこのチャンネルでは、最新の研究論文や論文執筆のコツをわかりやすくお伝えします。科学のワクワク感を共有し、一緒に新しい発見の旅に出かけましょう! Facebookはこちら→ https://www.facebook.com/EdanzJP/ 見たい、読みたい方向けに様々な方法で発信中→ https://jp.edanz.com/multimedia ブログはこちら→ https://jp.edanz.com/blog #バイオサイエンス #ルミノメーター開発 #医療資源不足 #オープンソース研究 ✅ 目次 0:00 スコット博士の自己紹介 1:15 既存のルミノメーターの特徴と問題点 1:56 開発された最新ルミノメーターの特徴と長所 2:30 スコット博士から見たこの研究の4つの長所
このエピソードでは、NASAでの技術開発に携わった経験を持つ化学のエキスパート、マイケル博士が、食べ物を通じて摂取する元素が草食動物の繁殖率に与える影響についての革新的な研究を解説します。研究の限界を記述する重要性や統計分析の重要性についての知識を得ることができます。最後までご覧いただき、科学的な洞察を深めてくださいね。 🔍このエピソードは以下の方にオススメです ・科学論文の執筆において、より効果的なコミュニケーションを目指す研究者 ・研究成果を国際的な学術誌で発表する予定の大学院生およびポスドク ・科学コミュニケーションに興味のある方々 ✅ チャンネルについて 科学の進歩は私たちの生活を豊かにし、未来を形作ります。マイケル博士のような一流の研究者から直接学べるこのチャンネルでは、最新の研究論文や論文執筆のコツをわかりやすくお伝えします。科学のワクワク感を共有し、一緒に新しい発見の旅に出かけましょう! Facebookはこちら→ https://www.facebook.com/EdanzJP/ 見たい、読みたい方向けに様々な方法で発信中→ https://jp.edanz.com/multimedia ブログはこちら→ https://jp.edanz.com/blog #化学 #科学研究 #論文執筆 #統計分析 #研究手法 ✅ 目次 0:00 マイケル博士の自己紹介 1:09 論文の魅力と研究テーマ 2:07 論文テーマの意外な新規性 2:59 ジャコウウシの食パターンと食事の元素構成から繁殖率への影響を調査 5:07 繁殖率に影響を与える元素とは? 5:36 論文の長所と参考すべき点は?
このエピソードでは、医学・健康科学の分野で著名なピーター博士が、脊髄損傷患者の運動能力を取り戻すための革新的な治療法についての研究成果を分かりやすく解説します。ピーター博士の豊富な経験と知見から、国際ジャーナルで注目される研究のポイントを学び、研究を世界に広めるための一歩を踏み出しましょう。 🔍このエピソードは以下の方にオススメです ・医学・健康科学の最新研究に関心を持つ研究者や学生 ・脊髄損傷治療法の進展に興味を持つ医療従事者 ・科学的知見を通じて、より良い未来を築きたいと考える一般の方々 ✅ チャンネルについて 科学の進歩は、私たちの生活を豊かにし、未来を形作ります。ピーター博士のような一流の研究者から直接学べるこのチャンネルでは、最新の研究論文や論文執筆のコツをわかりやすくお伝えします。科学のワクワク感を共有し、一緒に新しい発見の旅に出かけましょう! Facebookはこちら→ https://www.facebook.com/EdanzJP/ 見たい、読みたい方向けに様々な方法で発信中→ https://jp.edanz.com/multimedia ブログはこちら→ https://jp.edanz.com/blog #脊髄損傷 #医学研究 #臨床研究 #治療法 #医療情報 ✅ 目次 0:00 オープニング 0:32 硬膜外電気刺激の概要と課題 2:27 Nature Medicine誌に掲載された最新の硬膜外電気刺激プログラム 3:42 プログラムの効果とは 5:07 最新研究に寄せられる期待とインパクト
このエピソードでは、スイスでの10年間の献身的な研究を経て、白血病治療の最前線に立つマリア博士が、骨髄性白血病の最新治療法に関する画期的な研究成果を紹介します。臨床研究の論文構成をわかりやすく解説し、医学研究が私たちの健康と未来にどのように貢献するかを明らかにします。最後までご覧いただき、最新の医学知識を手に入れてください。 🔍このエピソードは以下の方にオススメです ・最新の医学研究に興味のある医療専門家 ・白血病治療法の進展を追いたい医学生や研究者 ・わかりやすい形で科学的知見を得たい一般の方々 ✅ チャンネルについて 科学のワクワク感を共有しませんか?心躍る新発見・研究の成果を、余すところなく伝え たい!という専門家集団エダンズが、最新の研究論文や論文執筆のコツをお伝えします! Facebookはこちら→ https://www.facebook.com/EdanzJP/ 見たい、読みたい方向けに様々な方法で発信中→ https://jp.edanz.com/multimedia ブログはこちら→ https://jp.edanz.com/blog #白血病 #医学研究 #臨床研究 #治療法 #医療情報 ✅ 目次 0:00:オープニング 0:32:骨髄性白血病(AML)の解説 1:45:RCTを用いた治療アプローチ 3:28:主要な分析結果よりも価値のあった補助分析結果 4:37:研究を解釈するための3つのポイント
このエピソードでは、英文論文のハイライトセクションを使って、あなたの研究を際立たせる方法を紹介します。魚の摂取量に関する最新の研究を例に、読者の注意を引き、記憶に残る論文を書くためのテクニックを解説します。 🔍このエピソードは以下の方にオススメです ・英文科学論文の執筆において、より効果的なコミュニケーションを目指す研究者 ・研究成果を国際的な学術誌で発表する予定の大学院生およびポスドク ・科学コミュニケーションに興味のある方々 論文のハイライトは、研究の「顔」とも言える部分です。このエピソードを通じて、あなたの研究がより多くの科学者たちの興味を引き、議論を呼ぶ契機になりますように。 ✅ チャンネルについて 科学のワクワク感を共有しませんか?心躍る新発見・研究の成果を、余すところなく伝えたい!という専門家集団エダンズが、最新の研究論文や論文執筆のコツをお伝えします! Facebookはこちら→ https://www.facebook.com/EdanzJP/見たい、読みたい方向けに様々な方法で発信中→ https://jp.edanz.com/multimedia ブログはこちら→ https://jp.edanz.com/blog #科学研究 #論文執筆 #ハイライト #研究手法 #英文論文 ✅ 目次 0:00 オープニング 0:28 ハイライト・キーポイントセクションとは? 1:41 魅力的なハイライトセクションを持つ論文の紹介 3:08 最新の研究の研究手法と結果は? 3:53 理想的なハイライトの構成を最新研究から解説
このエピソードでは、環境科学のエキスパートであるティナ博士が、「地球の限界を示すプラネタリー・バウンダリーの現状評価」に関する最新研究を分かりやすく解説します。また、この動画を通じて論文内で補足資料を使うメリットについても理解することができます。 🔍このエピソードは以下の方にオススメです ・科学論文の執筆において、より効果的なコミュニケーションを目指す研究者 ・研究成果を国際的な学術誌で発表する予定の大学院生およびポスドク ・科学コミュニケーションに興味のある方々 ✅ チャンネルについて 科学の進歩は私たちの生活を豊かにし、未来を形作ります。一流の研究者が発信するこのチャンネルでは、最新の研究論文や論文執筆のコツをわかりやすくお伝えします。科学のワクワク感を共有し、一緒に新しい発見の旅に出かけましょう! Facebookはこちら→ https://www.facebook.com/EdanzJP/ 見たい、読みたい方向けに様々な方法で発信中→ https://jp.edanz.com/multimedia ブログはこちら→ https://jp.edanz.com/blog #プラネタリーバウンダリー #地球の限界 #環境科学 #持続可能性 #科学コミュニケーション ✅ 目次 0:00 地球と身体のシステムは似たもの同士? 1:04 論文を多くの人に読んでもらうために 2:36 プラネタリー・バウンダリー(惑星境界/地球の限界)とは? 3:49 プラネタリー・バウンダリーの現状
このエピソードでは、栄養医学のエキスパートであるフィリッパ博士が、「マインドフルネスが食事療法の遵守率に与える影響」に関する最新研究を分かりやすく解説します。また、この動画を通じて無作為化比較実験(RCT)設計のコツについても理解することができます。 🔍このエピソードは以下の方にオススメです ・科学論文の執筆において、より効果的なコミュニケーションを目指す研究者 ・研究成果を国際的な学術誌で発表する予定の大学院生およびポスドク ・科学コミュニケーションに興味のある方々 ✅ チャンネルについて 科学の進歩は私たちの生活を豊かにし、未来を形作ります。一流の研究者が発信するこのチャンネルでは、最新の研究論文や論文執筆のコツをわかりやすくお伝えします。科学のワクワク感を共有し、一緒に新しい発見の旅に出かけましょう! Facebookはこちら→ https://www.facebook.com/EdanzJP/ 見たい、読みたい方向けに様々な方法で発信中→ https://jp.edanz.com/multimedia ブログはこちら→ https://jp.edanz.com/blog #マインドフルネス食事療法 #RCT設計 #生活習慣病管理 #健康心理学 ✅ 目次 0:00 マインドフルネスがDASH食事療法の遵守をサポート? 1:21 最新研究の治験プログラム 2:05 マインドフルネスと食事療法の驚きの関係 4:13 現実世界への応用は可能?
このエピソードでは、有機化学のエキスパートであるマイケル博士が、「揮発性有機化合物を介した菌類のコミュニケーション」に関する最新研究を分かりやすく解説します。また、この動画を通じて、レビュー論文を書く際のコツについても理解することができます。 🔍このエピソードは以下の方にオススメです ・科学論文の執筆において、より効果的なコミュニケーションを目指す研究者 ・研究成果を国際的な学術誌で発表する予定の大学院生およびポスドク ・科学コミュニケーションに興味のある方々 ✅ チャンネルについて 科学の進歩は私たちの生活を豊かにし、未来を形作ります。一流の研究者が発信するこのチャンネルでは、最新の研究論文や論文執筆のコツをわかりやすくお伝えします。科学のワクワク感を共有し、一緒に新しい発見の旅に出かけましょう! Facebookはこちら→ https://www.facebook.com/EdanzJP/ 見たい、読みたい方向けに様々な方法で発信中→ https://jp.edanz.com/multimedia ブログはこちら→ https://jp.edanz.com/blog #有機化学 #菌類コミュニケーション #化学物質 #レビュー論文の書き方 ✅ 目次 0:00 レビュー研究の有用性 1:07 揮発性化合物によるコミュニケーションとは? 2:28 揮発化合物によってコミュニケーションを取る菌類の生態系 3:34 レビュー研究をさらに魅力的にするためのテクニック
このエピソードでは、健康科学のエキスパートであるピーター博士が、「聴覚が認知能力に与える影響」に関する最新研究を分かりやすく解説します。また、この動画を通じて、治験を左右するサンプルサイズの設計についても理解することができます。 🔍このエピソードは以下の方にオススメです ・科学論文の執筆において、より効果的なコミュニケーションを目指す研究者 ・研究成果を国際的な学術誌で発表する予定の大学院生およびポスドク ・科学コミュニケーションに興味のある方々 ✅ チャンネルについて 科学の進歩は私たちの生活を豊かにし、未来を形作ります。一流の研究者が発信するこのチャンネルでは、最新の研究論文や論文執筆のコツをわかりやすくお伝えします。科学のワクワク感を共有し、一緒に新しい発見の旅に出かけましょう! Facebookはこちら→ https://www.facebook.com/EdanzJP/ 見たい、読みたい方向けに様々な方法で発信中→ https://jp.edanz.com/multimedia ブログはこちら→ https://jp.edanz.com/blog #聴覚認知研究 #サンプルサイズ設計 #人工内耳改善 #高齢者認知機能 ✅ 目次 0:00:難聴と認知力低下には関連性がある? 1:03:最新研究の実験型研究手法 2:21:研究結果:難聴改善は認知力の低下を防げるのか? 2:58:研究の医療ケア業界へのインパクトと今後の展望
このエピソードでは、バイオサイエンスのエキスパートであるスコット博士が、「G-タンパク質共役受容体(GPCR)の精製方法」に関する最新研究を分かりやすく解説します。また、この動画を通じて研究の限界に言及することの重要性についても理解することができます。 🔍このエピソードは以下の方にオススメです ・科学論文の執筆において、より効果的なコミュニケーションを目指す研究者 ・研究成果を国際的な学術誌で発表する予定の大学院生およびポスドク ・科学コミュニケーションに興味のある方々 ✅ チャンネルについて 科学の進歩は私たちの生活を豊かにし、未来を形作ります。一流の研究者が発信するこのチャンネルでは、最新の研究論文や論文執筆のコツをわかりやすくお伝えします。科学のワクワク感を共有し、一緒に新しい発見の旅に出かけましょう! Facebookはこちら→ https://www.facebook.com/EdanzJP/ 見たい、読みたい方向けに様々な方法で発信中→ https://jp.edanz.com/multimedia ブログはこちら→ https://jp.edanz.com/blog #GPCR精製 #バイオサイエンス #薬剤開発 #生物化学 ✅ 目次 0:00 GPCRと最新研究の概要 1:53 最新のGPCRの精製方法 2:15 GPCR精製の結果の紹介 3:25 研究の限界に言及することの重要性
このエピソードでは、環境・健康科学のエキスパートであるティナ博士が、「なぜ国によって平均睡眠時間が異なるのか?」について、指輪型デバイスを用いて、世界23万人の膨大なデータを集めた研究論文を紹介します。動画では、大規模なサンプルを集めるための工夫、大きく2つの要因が睡眠時間に影響を与えていることを解説しています。ぜひ最後までご覧ください。 🔍このエピソードは以下の方にオススメです ・科学論文の執筆において、より効果的なコミュニケーションを目指す研究者 ・研究成果を国際的な学術誌で発表する予定の大学院生およびポスドク ・科学コミュニケーションに興味のある方々 ✅ チャンネルについて 科学の進歩は私たちの生活を豊かにし、未来を形作ります。一流の研究者が発信するこのチャンネルでは、最新の研究論文や論文執筆のコツをわかりやすくお伝えします。科学のワクワク感を共有し、一緒に新しい発見の旅に出かけましょう! Facebookはこちら→ https://www.facebook.com/EdanzJP/ 見たい、読みたい方向けに様々な方法で発信中→ https://jp.edanz.com/multimedia ブログはこちら→ https://jp.edanz.com/blog #睡眠時間研究 #国別睡眠データ #環境健康科学 #ティナ博士 ✅ 目次 0:00 オープニング 0:31 国によって睡眠の長さは異なる? 1:31 最新技術を駆使した睡眠研究の方法とは? 2:41 何故睡眠時間は異なるのか? 3:21 今後の睡眠研究に向けてのポイント
このエピソードでは、栄養学のエキスパートであるフィリッパ博士が、ベジタリアンやビーガンが費用面で世の中にどう影響するか、について調べた「食事に隠された健康や生態系に対するコストを分析した最新の研究」を紹介します。この動画をご覧いただくことで、最もコスト削減効果が高い食事はなにか、持続可能な世の中にするためにできることはなにかを知ることができます。ぜひ最後までご覧ください 🔍このエピソードは以下の方にオススメです ・科学論文の執筆において、より効果的なコミュニケーションを目指す研究者 ・研究成果を国際的な学術誌で発表する予定の大学院生およびポスドク ・科学コミュニケーションに興味のある方々 ✅ チャンネルについて 科学の進歩は私たちの生活を豊かにし、未来を形作ります。一流の研究者が発信するこのチャンネルでは、最新の研究論文や論文執筆のコツをわかりやすくお伝えします。科学のワクワク感を共有し、一緒に新しい発見の旅に出かけましょう! Facebookはこちら→ https://www.facebook.com/EdanzJP/ 見たい、読みたい方向けに様々な方法で発信中→ https://jp.edanz.com/multimedia ブログはこちら→ https://jp.edanz.com/blog #栄養学 #ベジタリアン #持続可能性 #食事コスト ✅ 目次 0:00 オープニング 0:31 食事における健康・環境コストとは? 2:06 最もコスト削減効果が高い食事とは? 4:21 持続可能な食事を実現するためには? 5:05 論文を更に魅力的にするためのポイント
このエピソードでは、医学・健康科学のエキスパートであるピーター博士が、「テレリハビリテーションを支える活動認識の最新モデル」に関する最新研究を分かりやすく解説します。また、この動画を通じて、サステナブルな研究デザインを実現するためのコツについても理解することができます。 🔍このエピソードは以下の方にオススメです ・科学論文の執筆において、より効果的なコミュニケーションを目指す研究者 ・研究成果を国際的な学術誌で発表する予定の大学院生およびポスドク ・科学コミュニケーションに興味のある方々 ✅ チャンネルについて 科学の進歩は私たちの生活を豊かにし、未来を形作ります。一流の研究者が発信するこのチャンネルでは、最新の研究論文や論文執筆のコツをわかりやすくお伝えします。科学のワクワク感を共有し、一緒に新しい発見の旅に出かけましょう! Facebookはこちら→ https://www.facebook.com/EdanzJP/ 見たい、読みたい方向けに様々な方法で発信中→ https://jp.edanz.com/multimedia ブログはこちら→ https://jp.edanz.com/blog #テレリハビリテーション #活動認識技術 #リハビリテーション研究 #サステナブル研究 #医学革新 ✅ 目次 0:00 テレリハビリテーションの概要 1:08 テレリハビリテーションを支える活動認識技術 2:02 ディープラーニングと最新技術を用いた方法論 3:02 最新技術の活動認識能力 3:53 プライバシーに配慮した研究デザイン
このエピソードでは、医学・健康科学のエキスパートであるピーター博士が、「痛みを伴う治療を音楽で楽にすることはできるのか?」について、「大腸内視鏡検査に対するピアノ音楽の効果を検証した最新の研究」を用いて解説します。この動画をご覧いただくことで、ランダム化比較試験RCTの活用方法、研究をさらにより良いものにするためのヒントを得ることができます。ぜひ最後までご覧ください。 🔍このエピソードは以下の方にオススメです ・科学論文の執筆において、より効果的なコミュニケーションを目指す研究者 ・研究成果を国際的な学術誌で発表する予定の大学院生およびポスドク ・科学コミュニケーションに興味のある方々 ✅ チャンネルについて 科学の進歩は私たちの生活を豊かにし、未来を形作ります。一流の研究者が発信するこのチャンネルでは、最新の研究論文や論文執筆のコツをわかりやすくお伝えします。科学のワクワク感を共有し、一緒に新しい発見の旅に出かけましょう! Facebookはこちら→ https://www.facebook.com/EdanzJP/ 見たい、読みたい方向けに様々な方法で発信中→ https://jp.edanz.com/multimedia ブログはこちら→ https://jp.edanz.com/blog #音楽療法 #大腸内視鏡検査 #ランダム化比較試験 #医学研究 ✅ 目次 0:00 オープニング 0:32 大腸内視鏡検査の概要 1:45 RCTを用いた研究手法の紹介 2:22 ピアノ音楽を聴くと検査が楽に? 3:06 臨床現場への応用可能性は? 3:39 今後の研究の余地を提案
このエピソードでは、スイスで10年間、白血病の研究に従事したマリア博士が、「脳卒中予防で処方されるアスピリンの副作用が高齢者に与える影響」についての論文を紹介します。動画をご覧いただくことで、大規模なサンプルが必要な場合のポイント、治験をデザインするためのTips(ティップス)、アスピリンの副作用などの知見を得ることができます。 🔍このエピソードは以下の方にオススメです ・科学論文の執筆において、より効果的なコミュニケーションを目指す研究者 ・研究成果を国際的な学術誌で発表する予定の大学院生およびポスドク ・科学コミュニケーションに興味のある方々 ✅ チャンネルについて 科学の進歩は私たちの生活を豊かにし、未来を形作ります。一流の研究者が発信するこのチャンネルでは、最新の研究論文や論文執筆のコツをわかりやすくお伝えします。科学のワクワク感を共有し、一緒に新しい発見の旅に出かけましょう! Facebookはこちら→ https://www.facebook.com/EdanzJP/ 見たい、読みたい方向けに様々な方法で発信中→ https://jp.edanz.com/multimedia ブログはこちら→ https://jp.edanz.com/blog #脳卒中予防 #アスピリン副作用 #医学研究 #治験デザインTips ✅ 目次 0:00 オープニング 0:26 アスピリンの効果と副作用 1:46 大規模治験のデザイン 2:36 アスピリンが持つ副作用は実証されるか? 3:56 治験デザインの長所と改善点